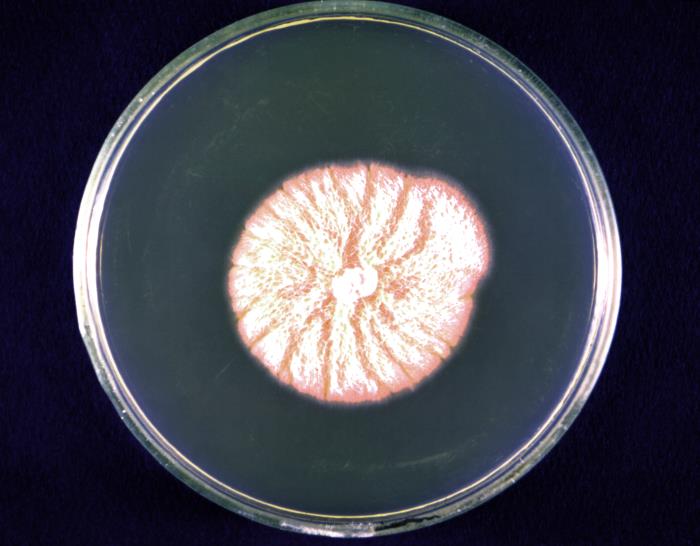
Colonia de Blastomyces dermatitidis. CDC Public Health Image Library (PHIL).Colonia de Blastomyces dermatitidis. CDC Public Health Image Library (PHIL).

Hongos
El RD 664/1997, de 12 de mayo, sobre la protección de los trabajadores contra los riesgos relacionados con la exposición a agentes biológicos durante el trabajo; expone en su artículo 2 que se entenderán por agentes biológicos los microorganismos, con inclusión de los genéticamente modificados, cultivos celulares y endoparásitos humanos, susceptibles de originar cualquier tipo de infección, alergia o toxicidad.
Los hongos son microorganismos eucariotas y pueden ser unicelulares (levaduras) o pluricelulares, formando estructuras filamentosas.
Muchos de ellos son considerados saprófitos, pero algunos pueden ser parásitos del hombre y ocasionar infecciones (micosis). Sin embargo, el principal efecto son las alergias provocadas por la inhalación, ingestión o contacto cutáneo de sus esporas. Estas reacciones alérgicas provocan una reacción inmunitaria exagerada en el individuo.
Algunos hongos producen además metabolitos secundarios conocidos como micotoxinas, que tienen efectos tóxicos. Entre las más relevantes se encuentran las aflatoxinas y las ocratoxinas. La exposición humana a micotoxinas se produce fundamentalmente por la ingestión de alimentos contaminados, aunque la exposición por vía inhalatoria y dérmica también es posible, ya que las micotoxinas forman parte de los bioaerosoles generados al manipular sustratos contaminados. Los efectos de las micotoxinas sobre la salud pueden ser inmunotóxicos, nefrotóxicos, hepatotóxicos, neurotóxicos, hemotóxicos, cancerígenos y mutágenos.
Algunas actividades laborales con riesgo son: actividades relacionadas con la producción de alimentos, el sector agrícola, el ganadero, trabajos de jardinería, recogida y tratamiento de aguas residuales, actividades sanitarias, el sector de la construcción, la industria extractiva y trabajos de explotación de la madera. En cuanto a enfermedades causadas por hongos, podemos destacar aspergilosis, blastomicosis, dermatofitosis, candidiasis, cromomicosis y absceso feomicótico.